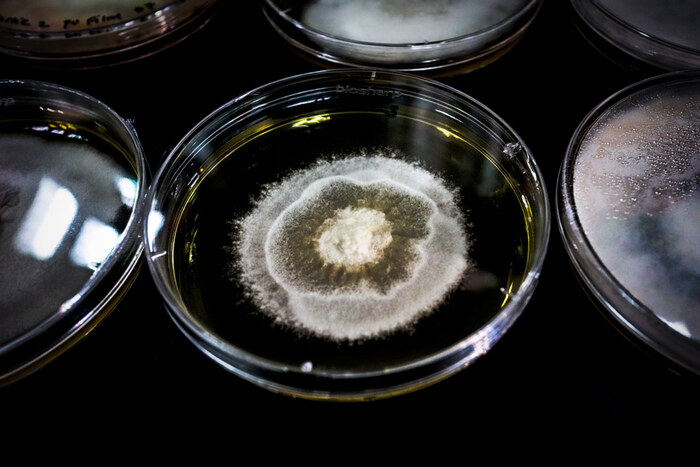

Говоря про ноотропы, практически невозможно пройти мимо ежовика гребенчатого. Грибная тема распространяется в сети, как и мицелий гриба, захватывающий новые территории. Порождая слухи и предрассудки. Пришло время проявить на свет некоторые детали.
На связи RISE: сообщество про эффективные способы повышения продуктивности. Инструментов для этого существует масса. Чаще всего я пишу про добавки и фарму. Но грибы и ежовик в частности - тема, которая часто всплывает в комментариях и вызывает вопросы, так что обратимся к ней ещё раз отдельно.
В чем сила ежовика?
Услышав фразу «грибы для мозга», кажется, что сейчас речь пойдет о чём-то, меняющем состояние сознания. Но мы не об этом. Ежовик не содержит психоактивных веществ. Вместо этого, он насыщен веществами, которые помогают создавать новые нейроны и нейронные связи, а именно так работает мозг под ноотропами.
Тот самый гриб-ноотроп
Ежовик, пирацетам и контрольная группа. По материалам исследования
Именно поэтому можно сравнить ежовик с ноотропами. Вообще, если рассматривать классическую связку доступных средств для нейрогенеза, то в неё войдут: рацетамы, бакопа Монье и ежовик гребенчатый. Именно ежовик и бакопа ценны тем, что повышают выработку нейротрофинов. Это такие белки, которые влияют на выживание, развитие и функционирование нейронов. Но при этом важно грамотно их использовать. Писал об этом в недавнем материале: инструкция биохакинга мозга.
Итак, гриб важен тем, что повышает фактор роста нервов (NGF). Этот фактор необходим для поддержания базальной холинергической системы переднего мозга. Фактор растет за счет гериценонов и эринацинов, выделенных из гриба. Эринацины и гериценоны — это растительные компоненты, скожие с нейрогормонами мозга, в частности с серотонином. За счет чегооказывают влияние на мозг. Концентрация этих элементов отличается между мицелием и самими плодами.
Можно ли ощутить действие ежовика или понять, он рабочий или нет? Увы, это сложность многих ноотропов. Не всегда их эффект чувствуется в моменте. Что касается конкретно ежовика — то лишь спустя время вы ощутите, что в памяти лучше отложились события и данные, с которыми вы встречались во время курса. Но за счет чего это происходит? Обратимся к исследованиям.
Особенности плодовых тел
Это не цветная капуста, а тот самый ежовик
Вот это исследование демонстрирует ценность плодовых тел ежовика. Речь идет о важном соединении — isohericerinol А. Именно он стимулирует NGF фактор в глиальных клетках. Более того, эффект этого соединения усиливается и другими компонентами гриба, как: hericerin, N-de-phenylethyl isohericerin и corallocin A.
Другое исследование сосредоточено вокруг эринацинов Z1 и Z2, которые отлично повышают выработку BDNF. Разница с приведенными выше компонентами в том, что Z1 и Z2 содержатся в редком виде ежовика: Hericium flagellum или Hericium alpestre.
Можно ли добыть эти эринацины и гериценоны не из гриба? В теории да, но именно тело ежовика содержит их в максимальной концентрации. Что касается Z1 и Z2 — они вообще уникальны в природе и содержатся именно в этом грибе, что и превращает ежовик гребенчатый в ноотроп.
Особенности мицелия
Узнали? Вот они, слева направо…
Мицелий ежовика также богат эринацинами. Вот это исследование показывает, что зерномицелий богат эринацинами, часть которых приведена на изображении выше. Более того, современные методы выращивания гриба позволяют делать это так, чтобы мицелий был максимально ими насыщен. Именно эринацины отвечают за нейрогенез и рост новых нейронных связей.
Логично, возникает вопрос: что лучше, плодовое тело или мицелий? Здесь уместно обратиться к мнению Михаила Вишневского, профессионального миколога. Он предлагает очень простую аналогию:
Гриб можно сравнить с яблоней. Тогда мицелий — это корни и ствол. А плодовые тела - сами грибы и яблоки.
Когда мы хотим яблок, мы не грызем ствол, а срываем плоды. В которых есть нужные нам компоненты.
В плодовых телах всегда будет больше компонентов, чем в мицелии.
Почему тогда мицелий так популярен? Здесь вопрос той же экономии. Мицелий разрастается огромными пластами, а после сбора урожая остается только его выбросить. Но зачем, если можно тоже продать? Тем более, небольшая доля полезных элементов все же останется. По сути, спор между мицелием и плодами сравним со спором, какой кофе лучше: арабика или робуста.
Личный опыт с ежовиком
Всего я пропил три курса ежовика. Брал у разных производителей. Сейчас тестирую тот, что на фото. Беру всегда комплекс: плодовые тела + мицелий. Соотношение между плодами и мицелием от 60/40 до 80/20. Что можно сказать по эффекту:
Меняются сны. После первой недели курса сны стали странными. Буквально в каждом из снов проваливался между измерениями, выпадал «за границы» реальности, видел как мир распадается на фракталы и собирается вновь. Эффект в общем неоднозначный.
Улучшается запоминаемость. Очень схоже с пирацетамом. Всё, что усваиваешь во время курса, надолго остается в памяти, и держится очень крепко.
Нет выраженного эффекта буста. Нет ощущения заряженности, продуктивности, дикой мотивации. И… этого ощущения не должно быть. Это нормально, что нет ярких ощущений, так как это ноотропный эффект, а не просто стимулирующий. Он и не должен вызывать разительных изменений в самочувствии.
Курс обычно беру на 30-40 дней. Оптимальные сроки. Быть может позже затестирую на долгосрок и отпишусь о результатах. А вы пробовали ежовик? Поделитесь, пожалуйста, мнением в комментариях.
Стоит ли ежовик возлагаемого на него эффекта?
Вот на это и будут влиять добавки типа ежовика: усиление нейрогенеза, то есть появления новых нейронов
Отвечу коротко: в принципе, можно попробовать экспериментировать с ежовиком, но на мой взгляд, это будет на уровне того же пирацетама или бакопы. Просто ежовик больше на слуху. Ждать от него откровений или разительных изменений в жизни не стоит. А вот ожидать легкого буста нейрогенеза — вполне реально.
Более подробно о том, как действуют другие ноотропные средства, препараты и добавки, читайте в материалах Телеграм сообщества и группы ВК. Подписывайтесь, чтобы первыми получать актуальные материалы!
Автор: Филипп Дончев, редактор сообщества RISE